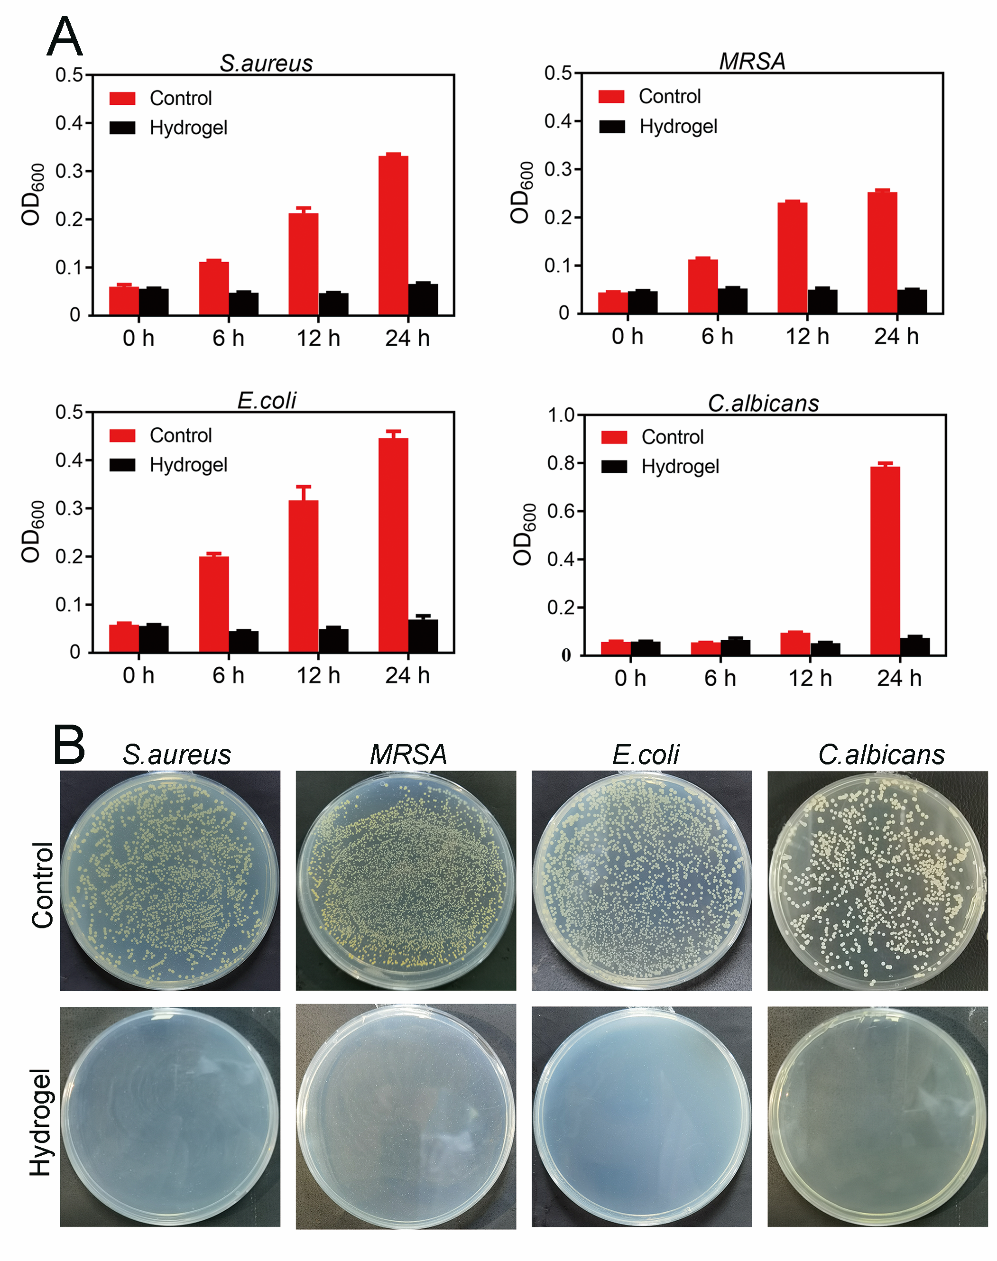

图1. J-1-ADP水凝胶的构建及应用
腹腔粘连是腹腔手术最为常见且严重的并发症,严重影响患者的健康状况和生活质量,目前临床上仍亟需发展有效的粘连预防及治疗措施。手术创伤、术后出血以及术后感染是组织粘连形成的主要诱因。当前,水凝胶材料由于其可注射性而可以覆盖不规则伤口,其在止血、伤口愈合和抗粘连等方面的应用引起了研究者的极大关注。近期,兰州大学基础医学院王凯荣教授课题组利用从蜜蜂蜂王浆中分离得到的天然抗菌肽J-1与腺苷二磷酸(ADP)溶液,在近生理pH环境通过多肽自组装为纳米纤维,进而交联成纳米纤维 网络而制备成J-1-ADP多肽水凝胶,该水凝胶的制备过程中没有添加任何化学交联剂 (如图2所示)。
图2. 抗菌肽J-1在10 mM的ADP钠盐中形成水凝胶。左图为水凝胶在小瓶中的形态,右图为该水凝胶的扫描电镜纤维结构。
抗菌肽J-1具有良好的广谱抗菌活性,而ADP是最早发现,也是人体内最重要的能诱导血小板聚集的物质,其可激活血小板,诱导血小板聚集而加速凝血过程。该制备策略将抗菌肽的抗菌活性和ADP的凝血活性赋予了该水凝胶,其对革兰氏阳性菌株 S. aureus,及其耐药株MRSA, 革兰氏阴性菌株 E. coli,真菌 C. albicans都表现了良好的抑菌/杀菌活性(如图3所示);在体外凝血试验及小鼠肝脏出血模型中均表现了良好的凝血性能(如图4所示);该水凝胶在大鼠腹壁缺损-盲肠磨损动物模型中显示了良好的防粘连活性(如图5所示)。此外,由于该水凝胶是由天然活性肽与生理活性物质通过物理交联而制成,因此其具有良好的生物相容性 (如图6所示)。因此,该研究可能为功能多肽水凝胶的设计、合成提供一种新的策略,或可为预防临床术后粘连提供一种替代材料。
图3. J-1-ADP水凝胶对金黄色葡萄球菌、MRSA、大肠杆菌和白色念珠菌的增殖及菌落形成的影响。

图4. J-1-ADP水凝胶的体外、体内凝血实验。A,B,C,D分别为水凝胶的全血凝血,血浆凝血,血小板激活及血小板粘附实验;E为小鼠肝脏出血模型凝血实验,F为凝血时间,G为出血质量。

图5. J-1-ADP水凝胶在大鼠腹壁缺损?盲肠磨损模型中抗粘连作用。A为术后7天,14天腹壁粘连的代表图片;B,C为不同组的术后粘连评分。

图6. J-1-ADP水凝胶的生物相容性实验。A,B,C为其血液相容性研究;D,E为其与哺乳动物细胞相容性研究;F和G为其免疫相容性研究。
该项工作以“An Injectable Peptide Hydrogel Constructed of Natural Antimicrobial Peptide J-1 and ADP Shows Anti-Infection, Hemostasis, and Anti-Adhesion Efficacy” 为题发表在 ACS Nano 上(ACS Nano 2022, DOI:10.1021/acsnano.1c11206)。文章第一作者是兰州大学基础医学院2018级博士研究生周静静,2019级博士研究生张翰儒为共同第一作者,兰州大学基础医学院王凯荣教授和阎文锦教授为该论文通讯作者。该研究得到了中国医学科学院多肽研究创新单元医学与健康科技创新工程项目,国家自然科学基金委员会和甘肃省自然科学基金项目的支持。
原文链接:https://pubs.acs.org/doi/10.1021/acsnano.1c11206